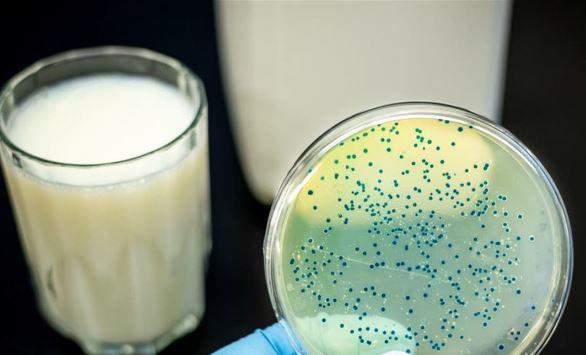

أعمال التخريب تجتاح هولندا وتطال مراكز فحوص كورونا
خبرني - شهدت عدة مدن هولندية أعمال نهب وتخريب واشتباكات مع الشرطة، خلال مظاهرات منددة بحظر التجول، الذي فرض منذ يوم السبت لمكافحة تفشي وباء كورونا.
خبرني - شهدت عدة مدن هولندية أعمال نهب وتخريب واشتباكات مع الشرطة، خلال مظاهرات منددة بحظر التجول، الذي فرض منذ يوم السبت لمكافحة تفشي وباء كورونا.
خبرني - قال شهود ووسائل إعلام محلية إن مواجهات ليلية عنيفة بين الشرطة وشبان اندلعت في ست مدن تونسية على الأقل من بينها العاصمة تونس ومدينة سوسة الساحلية وس
خبرني - كشف مكتب الإحصاءات الوطنية البريطاني أرقاما صادمة، تكشف مدى تفشي فيروس كورونا المستجد في البلاد. وقال رئيس الوزراء البريطاني بوريس جونسون،

موقع خبرني - عاجل التفاصيل الكاملة حول: وفاتان بحرائق تجتاح الجزائر - صور، تابعوا اخر الاخبار المحلية العاجلة في الاردن على مدار الساعة يومياً.

موقع خبرني - عاجل التفاصيل الكاملة حول: الموجة الثانية لكورونا تجتاح كندا، تابعوا اخر الاخبار المحلية العاجلة في الاردن على مدار الساعة يومياً.
موقع خبرني - عاجل التفاصيل الكاملة حول: بكتيريا جديدة تجتاح الصين، تابعوا اخر الاخبار المحلية العاجلة في الاردن على مدار الساعة يومياً.

موقع خبرني - عاجل التفاصيل الكاملة حول: موجة إفلاس كبرى تجتاح اميركا ، تابعوا اخر الاخبار المحلية العاجلة في الاردن على مدار الساعة يومياً.

أسفرت العاصفة كارمن، وهي الثالثة التي تضرب غرب أوروبا هذا الموسم، عن سقوط قتيل في فرنسا، حيث توقعات الأرصاد رياحا ليلة رأس السنة تصل سرعتها إلى 140 كلم في الساعة.

تقرير.. حرائق تجتاح عدة مناطق بدولة الاحتلال الصهيوني